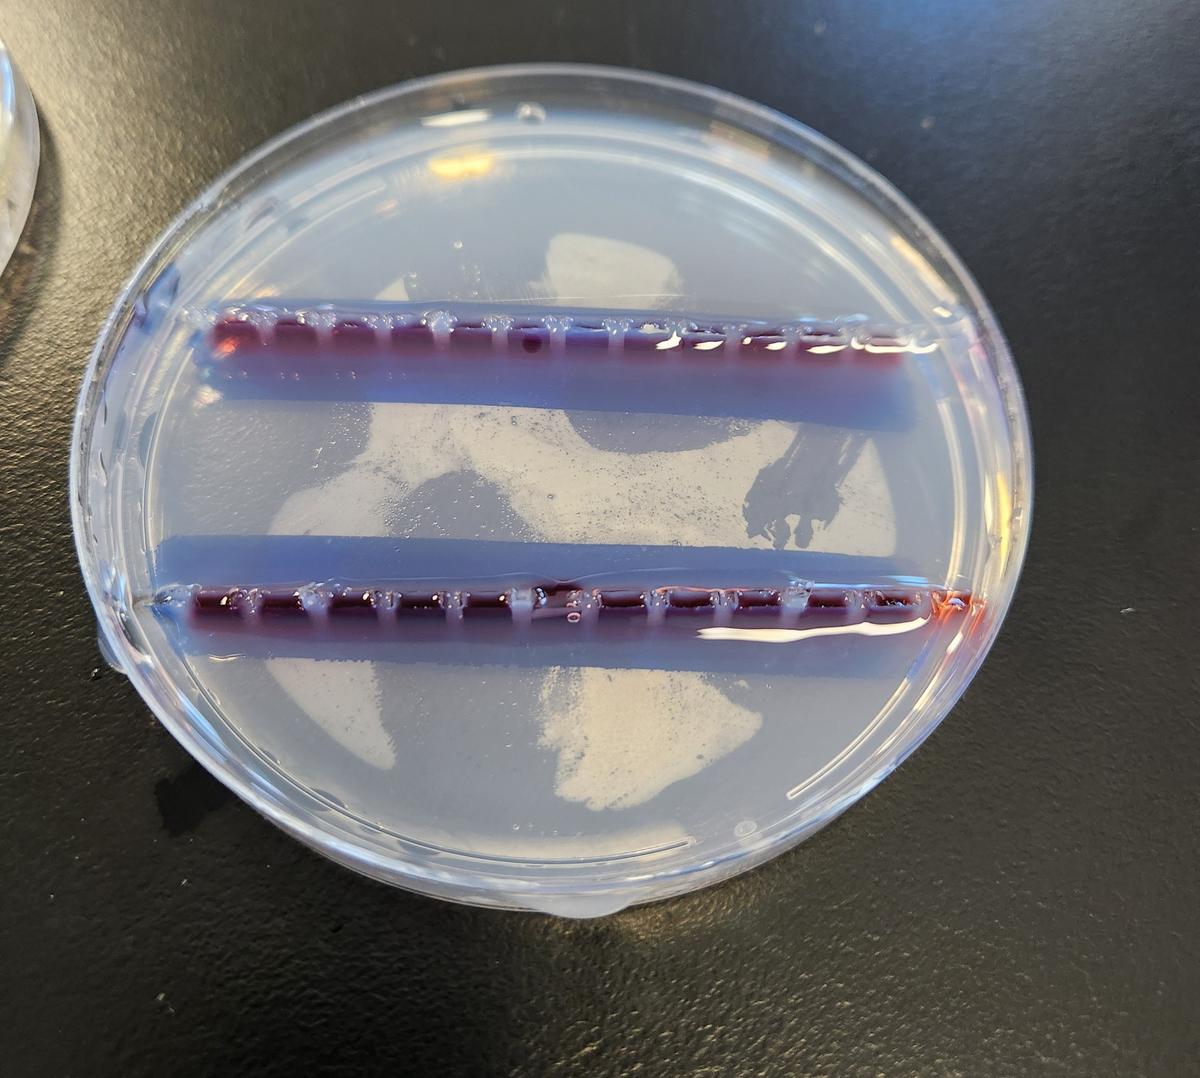
Gallery Image

Teaching & Learning News

Biology
Students in our HSC Biology class recently had the exciting opportunity to step into the world of advanced genetics as part of their Heredity unit. Using university-level laboratory equipment provided by the University of Sydney, they developed practical skills that mirror those used by real scientists.
During the investigation, students performed electrophoresis to analyse DNA samples and diagnose a simulated case of sickle cell anaemia, comparing the genetic profiles of a baby with those of its parents. They also gained hands-on experience using micropipettes to accurately transfer tiny samples of DNA, building precision and confidence in laboratory techniques.
This experience provided students with valuable insight into modern genetic testing and strengthened their understanding of key concepts in heredity.
English
Mrs Little's Year 9 English class participated in Blackout Poetry as part of their Voices of War Poetry unit. Students were given a page from a book and challenged to create a poem using only the words present on that page. The results, as you can see, demonstrate the students' creativity and skill in this exercise.
Hospitality
The Year 12 Certificate II Hospitality students successfully completed their assessment on coffee and non-alcoholic beverages yesterday. Well done everyone!
Work Experience
The canteen has welcomed a new assistant, Tristan, who will be participating in a work experience program every Thursday. We extend a warm welcome to him as he joins the team!
Agriculture
Tenterfield High School participated in the Tenterfield Show
Biology
Ms Parker's Yr11 Biology class launching into Microbiology skills.
Technology
Mr Sproule's Year 8 Technology students are currently honing their chisel skills in today's practical lesson.
Mrs Cooper's Year 7 students enjoyed their first practical lesson in the kitchen, where they prepared delicious cheese and bacon rolls. Fantastic job, everyone!
Year 9/10 Food Tech students created gluten free chicken schnitzels in their practical lesson with Mrs Cooper.
Mrs Cooper's Year 9/10 Food Technology students presenting their grazing plate assessment tasks.
Mr Sproule's Yr 9/10 Metal students have been working on their rocket stove and toolbox projects this term.
Visual Arts
Congratulations to our students for their outstanding entries in the Tenterfield Show! A special shout-out to Shay for winning First Prize. Well done!